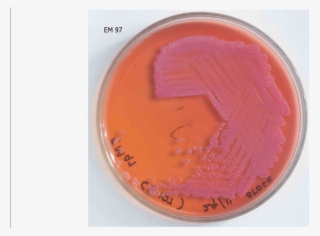
Pseudomallei Cultured In Macconkey Agar - Coin #9908589

-
135341 Rev-570 - 5 Cents Coin Canada
570*570
1
1
-
Ladies, Purses - Coin Purse
600*950
2
1
-
Customer Reviews - Coin Purse
960*576
2
1
-
Pencil Case $2 Smålish Dållars - Coin Purse
2000*1500
2
1
-
Degussa Thaler "1 - Coin
1276*1276
2
1
-
Barber Dime - Coin
561*576
1
1
-
Coin
700*700
1
1
-
French Small Flag Badge - Coin Purse
572*541
1
1
-
2019 Silver 1oz Coin
624*652
2
1
-
General Maintenance - Sweat Coins
640*640
2
1
-
Out Of Stock - Coin Luck 2017
600*600
2
1
-
Get Your Customs Valuation - Coin
750*796
2
1
-
Coin
600*517
2
1
-
Leather Journal Cover - Coin Purse
800*641
1
1
-
Silver Us Coins
1200*1200
1
1
-
Image Of "graveyard" - Enlisted Jesus Coin
1000*1000
2
1
-
Asteroid - Gold Coin Pixel Art
1060*610
2
1
-
Coin Purse
600*600
1
1
-
Canadian Silver Coin Universe
570*570
2
1
-
Mini Block Wallet - Coin Purse
869*1067
1
1
-
Coin Purse
1575*1050
2
1
-
Coin Purse
1000*913
1
1
-
Coin Purse
800*600
2
1
-
Pokemon- Pikachu Zipper Wallet - Coin Purse
960*942
2
1
-
Rustic Blue - Coin Purse
4209*2476
0
0
-
Pseudomallei Cultured In Macconkey Agar - Coin
850*504
0
0
-
Lovebirds - Coin Purse
960*960
0
0
-
Philharmonic Gold Coin
600*600
0
0
-
Nebula Fractal Space Png - Coin Purse
991*531
0
0
-
Super Mario Level Up - Sock
2048*2048
0
0
-
Potcoin - Potcoin Coin Logo
581*581
2
1
-
Skycoin Cloud Logo Blue - Skycoin Coin Logo
1600*1600
2
1
-
Cosmetics
1024*529
0
0
-
Coin Stack Coins - Adventures Of Bobby Orde
977*1069
3
1
-
Lakshmi Gold Coin Coins - Dollar Sign Rectangle Magnet
1409*1751
4
1
-
Coin Coins Objects - Duke Nukem Forever Box Art
648*480
3
1
-
Euro Coin Coins
563*564
3
1
-
Part Of The Super Mario Bros
768*768
3
1
-
2019 Australian Kangaroo 1oz Silver Coin
900*900
2
1
-
Coins Png Clip Art
4130*6000
2
1
-
Coins Money Svg Clip Arts 600 X 555 Px
600*555
3
1
-
Tiny Sun Coin Necklace - Locket
939*1024
3
1
-
Piggy Bank Coin Money Bag - Piggy Bank Clipart
750*750
6
1
-
Stacks Of Coins Transparent Png - Money
1280*1260
7
1
-
Dollar Sign Bank Currency Symbol Coin - Payment
1500*1500
3
1
-
Gold Coins In Pot Png Image - Pot Of Gold
800*800
4
1
-
Yoda Silver Niue Coin - Star Wars Niue 2012
455*455
5
1
-
Silver Numismatic Star Wars Ships - Star Wars
500*500
4
1
-
Roberto Coin Diamonds By The Inch 18k Yellow - Necklace
1600*1600
4
1
-
Happy Diwali 10 Gm, 999 Precious Silver Coin - Product
1632*1569
3
1
-
Palm Coin Lig Patch Soft Mesh Back Cap
570*570
3
1